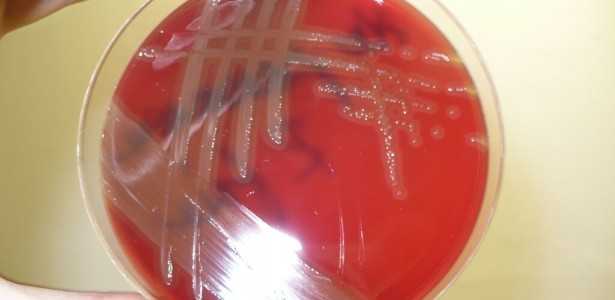
Análise do Mecanismo de Resistência da Bactéria Causadora de Pneumonia e Meningite

Estudo Revela Novo Ponto Fraco do Pneumococo na Luta contra Ingressos Antimicrobianos
Um novo estudo publicado na Scientific Reports analisa o papel da proteína de superfície A (PspA), produzida pelo pneumococo (Streptococcus pneumoniae), que age como uma defesa contra os mecanismos imunes do hospedeiro. A pesquisa investigou a interação do pneumococo com a indolicicina, um peptídeo antimicrobiano (AMP) de origem bovina com potencial terapêutico.
O Papel dos Peptídeos Antimicrobianos
Os peptídeos antimicrobianos, também conhecidos como defensinas, são moléculas críticas na luta contra diversos patógenos, incluindo vírus, bactérias e fungos. A crescente resistência a antibióticos tem agravado o tratamento de infecções por pneumococo, impulsionando a busca por novas opções terapêuticas.
Leia Também
Resultados Importantes da Pesquisa
Os pesquisadores, liderados pela doutora Michelle Darrieux Sampaio Bertoncini da Universidade de São Paulo (USP), descobriram que pneumococos mutantes que não produzem PspA são mais suscetíveis à ação da indolicicina. A remoção química da proteína PspA aumenta a eficácia desse antimicrobiano, o que sugere que a PspA interage diretamente com a indolicicina. A relação entre essas moléculas foi confirmada por espectrometria de massas.
Além disso, a presença de anticorpos contra a PspA aumentou a taxa de morte bacteriana induzida pelo AMP, o que indica que essa proteína desempenha um papel essencial na proteção do pneumococo contra indolicicina, sequestrando o antimicrobiano e dificultando sua penetração na membrana da bactéria.
Implicações para o Desenvolvimento de Novas Terapias
As descobertas deste estudo, apoiado pela FAPESP, têm o potencial de contribuir significativamente para o desenvolvimento de novas vacinas e tratamentos contra o pneumococo, que é responsável por aproximadamente 1 milhão de mortes anuais mundialmente, afetando mais gravemente crianças e idosos.
O artigo completo pode ser acessado em: Scientific Reports – Pneumococcal Surface Protein A (PspA) Prevents Killing of Streptococcus pneumoniae by Indolicidin.
Conclusão
A pesquisa destaca a importância da PspA como um alvo potencial para novas intervenções terapêuticas no combate a infecções pneumocócicas. Com a identificação de novos mecanismos de resistência, a ciência avança em direção à implementação de alternativas eficazes em um cenário crescente de resistência a medicamentos.
Informações da Agência FAPESP